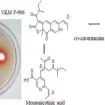

According to a new study published today in AGU Advances, the organization's journal for high-impact, open-access research and commentary across
In the Gulf of Aqaba, a branch of the Red Sea, an earth scientist from the University of Miami Rosenstiel School of Marine and Atmospheric Science found evidence of an